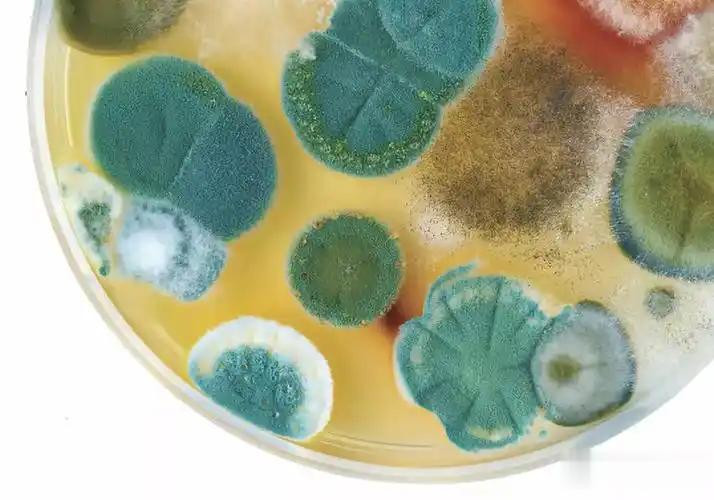

在医学史的星空中,有些名字的光线格外小心——他们不仅扶直了无数生命,更绝对改动了东说念主类扞拒疾病的花式。亚历山大·弗莱明(Alexander Fleming)无疑是其中之一。1928年9月的一个朝晨,这位苏格兰细菌学家在伦敦圣玛丽病院的实验室里,通过一次看似巧合的不雅察,发现了一种自后被称为“青霉素”的神奇物资。这一发现开启了抗生素时期,将东说念主类从细菌感染的死一火威逼中摆脱出来。他被后世尊为抗生素规模的前驱,与霍华德·弗洛里(Howard Florey)、恩斯特·钱恩(Ernst Chain)共同得回1945年诺贝尔生理学或医学奖。
从苏格兰农场到伦敦实验室
1881年8月6日,亚历山大·弗莱明出身在苏格兰艾尔郡洛赫菲尔德(Lochfield)的一个农场家庭。他是家中八个孩子中的第七个,父亲休·弗莱明(Hugh Fleming)是农民,母亲格蕾丝·斯特林·莫顿(Grace Stirling Morton)是父亲的第二任内助。在农场上渡过的童年,培养了他敏感的不雅察力和对当然的酷好心——这些品性自后成为他科学发现的重要基础。
7岁时,父亲死一火,母亲与继兄共同料理农场。弗莱明在当地学校袭取基础造就后,13岁时跟班已是大夫的继兄前去伦敦。他在居摄街理工学院(Regent Street Polytechnic)完成学业,期间曾在航运公司作念职员,并在布尔接触(1899-1902)期间片霎投军,但未参加战斗。
1901年,弗莱明赢得奖学金,进入伦敦帕丁顿的圣玛丽病院医学院(St. Mary‘s Hospital Medical School)。1906年,他得回表里科学士学位后,留在圣玛丽病院,加入由阿尔姆罗斯·赖特爵士(Sir Almroth Wright)教养的接种部(Inoculation Department),担任助理细菌学家。赖特是免疫学和疫苗疗法的前驱,他投诚通过疫苗疗法增强东说念主体自身免疫系统,而非依靠化学药物。在赖特的带领下,弗莱明培养了严谨的究诘魄力,深入探索细菌与东说念主体免疫的关系。
1908年,弗莱明得回细菌学学士学位,成为医学生的讲师。同庚,他通过给梅毒患者打针保罗·埃尔利希(Paul Ehrlich)新合成的药物“洒尔佛散”(Salvarsan)积攒了临床告戒,成果令东说念主惬心,尔后他一直为宽裕的梅毒患者督察着一个小限制但利润可不雅的诊疗业务。

接触的浸礼:扞拒感染的发蒙
1914年,第一次宇宙大战爆发。弗莱明动作伦敦苏格兰志愿团的成员,以中尉军官身份加入皇家陆军医疗队。1917年晋升上尉。他被派往法国布洛涅(Boulogne)的战地病院,在赖特教养的一个迥殊伤口究诘实验室责任。
战场上的资格深深颠簸了弗莱明。在佛兰德斯战场,士兵的伤口频频沾染土壤,跟着高速兵器切入身段,感染后果极为严重。那时莫得抗生素,大夫只可用消毒剂处理伤口,如碘酒和石炭酸。可是,弗莱明的究诘证明,这些化学消毒剂无法浸透到深部伤口杀死扫数无益细菌,反而会杀死东说念主体自身的白细胞——身段的第一起防地,执行上可能加重组织毁伤。他不雅察到,脓液本人具有抗菌才调。这一发现发表在1917年的《柳叶刀》(Lancet)上,但并未引起前哨大夫的庸俗爱重。他建议使用高浓度盐水冲洗深部伤口,但这一理念在那时未得到聘任。
接触竣事后,弗莱明回到圣玛丽病院,无间究诘白细胞和防腐剂。这段资格让他真切领悟到,东说念主类进击需要一种省略特异性杀死细菌而不伤害东说念主体细胞的药物。

溶菌酶的发现:前奏曲
1921年,弗莱明取得了另一个重要发现——溶菌酶(lysozyme)。有一次,他伤风流鼻涕,一滴鼻水点在了培养细菌的培养皿上。几周后他诧异地发现,鼻水周围的细菌被溶化隐没了。进一步究诘发现,东说念主类血清、泪水、唾液、乳汁以及好多其他体液中皆存在这种能溶化细菌的物资。
溶菌酶的发现证明,东说念主体自身领有抗菌物资。缺憾的是,溶菌酶在自然气象下对无害的空气传播细菌成果较好,但对致病菌成果有限。试图浓缩它以增强抗菌性能的努力也未能得胜。尽管如斯,这一发现西宾了弗莱明敏感的不雅察力,为他自后识别青霉素的作用奠定了基础。

1928年9月3日:改动历史的一天
1928年9月3日,弗莱明竣事了两周的假期,从苏格兰回到圣玛丽病院的实验室。度假前,他在责任台上堆放着好多培养葡萄球菌的培养皿,莫得全部放进恒温箱。
当今,他运转清算这些培养皿。一个征象收拢了他的眼神:其中一个培养皿被霉菌欺侮了,长出一团青色的霉斑。更奇怪的是,在霉菌周围,有一圈透明的区域——蓝本助长的葡萄球菌菌落隐没了,仿佛被某种力量“溶化”了。
淌若是一个放浪的究诘者,可能会唾手将这个被欺侮的培养皿扔掉。但弗莱明莫得。他的助手说培养基被欺侮了,申请倒掉它,弗莱明却仔细不雅察后说了一句驰名的话:“这很道理。”他敏感地意志到,这种霉菌可能分泌了某种杀死细菌的物资。
他将霉菌辞别出来进行纯培养,发现这种霉菌属于青霉菌属(Penicillium),自后被轻狂为特异青霉(Penicillium notatum)。他将这种霉菌产生的抗菌物资定名为“青霉素”(penicillin)。

初步探索:青霉素的杀菌才调
弗莱明随后进行了一系列实验。他用含有青霉素的肉汤培养液进行稀释进修,发现即使稀释800倍,仍能遏止葡萄球菌和肺炎球菌的助长。它还能杀死链球菌、脑膜炎球菌、白喉杆菌等多种无益细菌,但对伤寒杆菌和大肠杆菌无效。
最要害的是毒性进修。弗莱明将青霉素打针到兔子的血管里,不雅察反映,截止兔子巩固无恙,莫得任何额外。这证据青霉素对东说念主体细胞莫得彰着毒性——这恰是他一直在寻找的“完满抗菌剂”的特色。
1929年2月13日,弗莱明在医学究诘俱乐部(Medical Research Club)求教了他的发现,听众反映冷淡。1929年6月,他在《英国实验病理学期刊》(British Journal of Experimental Pathology)上厚爱发表了论文,求教了青霉素的抗菌作用和潜在休养价值。但科学界相似简直莫得反映。

难以跳跃的膺惩:提纯的逆境
弗莱明遭受了无法克服的辛勤。青霉素极不踏实,在室温下放置时间长了就会碎裂,失去杀菌作用。他和助手斯图尔特·克拉多克(Stuart Craddock)、弗雷德里克·雷德利(Frederick Ridley)尝试辞别纯品,但均告失败。他们只可用粗提取物进行局部外敷休养溃疡等皮肤感染,无法制备足量、皎洁、可用于全身打针的药物。
1932年,克鲁德布科(Clutterbuck)和1935年瑞德(Reid)也尝试提取青霉素,发现它不踏实后合计不合适用作抗感染药物。那时磺胺类药物正在兴起,蛊卦了广宽究诘者的眼神。青霉素就这么被放手了。
弗莱明本东说念主也莫得完全意志到青霉素的浩大后劲。他自后承认,ued中国官网由于提纯辛勤,加上他合计诊治来自身段里面而非外部药剂,因此主要将青霉素视为局部防腐剂和实验室平辞别某些细菌的用具。1936年,他在第二届外洋微生物学大会上再次提议青霉素的可能,但依然被冷落。

被渐忘的先驱:塞西尔·佩因的临床尝试
在弗莱明发现青霉素后不久,一位名叫塞西尔·乔治·佩因(Cecil George Paine)的大夫曾尝试临床诓骗。佩因在学生时期听过弗莱明的求教,对青霉素产营业思意思。参加责任时,他写信向弗莱明索求了青霉菌样品。
1930年,佩因将含有青霉菌的培养液滴入一个三个月大、眼睛被淋球菌感染的婴儿眼内。11月25日的医疗记载写着“运转使用青霉素”,到了12月2日,婴儿的眼睛依然干净,化脓隐没。佩因回忆:“青霉素如同魔咒一样起效了。”他还用访佛法子诊治了一位被石头碎屑刺穿眼球、感染肺炎球菌的矿工。
令东说念主怅然的是,1931年3月,佩因去了伦敦究诘产后热,再未使用青霉素。他可能是宇宙上第一个在临床推论中证明青霉素休养价值的东说念主,但错过了改动历史的契机。晚年袭取采访时,他缺憾地说:“一个珍爱的蠢货,当青霉素就在他眼前时,我莫得看见。”

牛津大学的戮力:从新奇物资到救命神药
1939年,第二次宇宙大战爆发。德国化学家恩斯特·钱恩(Ernst Chain)在古书堆里看到了弗莱明1929年的论文,运转进行提纯实验。他与牛津大学威廉·邓恩病理学院的霍华德·弗洛里(Howard Florey)造就构成团队,还有生物化学家诺曼·希特利(Norman Heatley)和爱德华·亚伯拉罕(Edward Abraham)等加入。
牛津团队濒临浩大挑战。那时每周需要处理多达500升的霉菌滤液。他们运转使用浴盆、便盆、牛奶罐、食物罐等迥殊规容器培养霉菌,还雇佣女孩以每周2英镑薪资负责接种和发酵责任。希特利发明了逆流提取法,将青霉素提取到乙酸戊酯中再溶化回水中,培植了产量。亚伯拉罕使用氧化铝柱色谱技能去除杂质。
1940年5月,弗洛里进行了一项要害实验:给50只小鼠打针致命剂量的链球菌,其中25只打针青霉素,25只作对照。截止打针青霉素的24只存活,对照组的25只全部死一火。这是青霉素初度在动物实验中证明能诊治全身性感染。
第一位病东说念主的悲催与朝阳
1941年2月12日,一位43岁的观看阿尔伯特·亚历山大(Albert Alexander)成为第一个袭取牛津大学青霉素打针的东说念主。他在修剪玫瑰时划伤嘴角,发生链球菌和葡萄球菌夹杂感染,浩大的脓肿侵袭了眼睛、脸部和肺部,生命弥留。
大夫为他打针青霉素,几天后病情显贵改善,体温下跌,脓肿消退。可是,药物很快就用光了——那时只可从尿液中回收极少青霉素。亚历山大在几天后倒霉离世。此次休养固然失败,但明确表现了青霉素的惊东说念主成果。
自后的临床进修更多用于儿童,因为他们需要剂量较小,截止证明得胜。

远渡重洋:好意思国的大限制出产
英国正在资格二战最劳作时期,化学工业全力参预接触需求,无法大限制出产青霉素。1941年夏天,在洛克菲勒基金会资助下,弗洛里和希特利前去好意思国。
他们与伊利诺伊州皮奥里亚的好意思国农业部朔方地区究诘实验室(NRRL)建造相干。这里领有先进的发酵技能。安德鲁·莫耶(Andrew Moyer)发现,用乳糖代替蔗糖可培植青霉素产量,加入玉米浆更是将产量培植10倍。皮奥里亚实验室还筛选出更合适深层培养的菌株。
最令东说念主嘉赞的是,产量最高的菌株居然来自皮奥里亚生果阛阓的一个发霉的哈密瓜。实验室助理玛丽·亨特(Mary Hunt)带来的这个“布满金黄色霉菌”的瓜,被轻狂为产黄青霉(Penicillium chrysogenum),产量远高于弗莱明的特异青霉。自后用X射线和紫外线照耀诱变,产量进一步培植。
好意思国制药公司如默克(Merck)、施贵宝(Squibb)、礼来(Lilly)、辉瑞(Pfizer)等加入研发和出产。1941年10月和12月,科学究诘与发展办公室(OSRD)医学究诘委员会召开会议,调解调解。1943年,青霉素成为好意思国仅次于原枪弹的第二重要高端究诘名堂。到1944年6月诺曼底登陆时,出产的青霉素已宽裕休养扫数受伤友军士兵。接触竣事时,好意思国公司每月出产6500亿单元青霉素。
青霉素的成果立竿见影。第一次宇宙大战期间,细菌感染占死一火东说念主数的近20%;第二次宇宙大战期间,这一比例降至不及1%。

迟来的荣誉:诺贝尔奖
1945年,亚历山大·弗莱明、霍华德·弗洛里和恩斯特·钱恩共同得回诺贝尔生理学或医学奖。这是对三位科学家各自孝敬的平允认同——弗莱明发现了青霉素并领悟到其后劲,弗洛里和钱恩将其发展成可庸俗使用的休养药物。
弗莱明在诺贝尔演讲中转头了1921年溶菌酶的发现,指出这才是第一个被发现的抗生素。他将我方的得胜归于运说念和不雅察力:“在我醒来后的黎明时期,1928年9月28日,我十足莫得洽商通过发现宇宙上第一种抗生素或杀菌剂来绝对改动扫数医学。但我思这恰是我所作念的。”
除了诺贝尔奖,弗莱明还得回无数荣誉。1944年,他被英国国王乔治六世封为爵士,成为亚历山大·弗莱明爵士。他得回多所大学荣誉博士学位,入选繁密驰名科学学会。
1955年3月11日,弗莱明在伦敦灭尽,享年73岁。他被安葬在圣保罗大教堂,与英国其他伟东说念主相伴。

被冷落的孝敬者:诺曼·希特利
值得谨记的还有诺曼·希特利。动作牛津团队的中枢成员,他发明了要害的提取法子,使青霉素提纯成为可能。由于诺贝尔奖频繁只授予三东说念主,希特利未能获奖。直到1990年,诺贝尔委员会才授予他荣誉医学博士学位——这是诺贝尔奖历史上第一次。
长久的遗产:抗生素时期的开启
青霉素的发现和诓骗,绝对改动了医学。
在此之前,肺炎、脑膜炎、败血症、淋病、风干冷等皆是致命疾病。大夫面对感染简直窝囊为力,只可为病东说念主祷告。青霉素问世后,这些也曾可怕的疾病变得不错休养。
它创始了抗生素的黄金时期。青霉素的得胜刺激了制药公司筛选其他自然居品的抗菌活性。链霉素、四环素、红霉素、永劫霉素等接踵被发现,构建了东说念主类扞拒细菌感染的强劲兵器库。1900年,人人平均寿命约47岁;到20世纪末,发扬国度平均寿命已培植到78岁,抗生素的孝敬功不成没。
青霉素还改动了外科推论。术后感染风险大幅裁减,好多蓝本高风险的手术成为成例操作。器官移植、腹黑手术、要害置换等当代医学古迹,皆离不开抗生素的添砖加瓦。
青霉素的发现进程也成为科学史上的典范——它展示了巧合不雅察与有准备的头脑集中的力量。弗莱明本东说念主说:“任何要紧发现皆是势必的巧合,这种巧合只留给那些有心东说念主。”

尾声:今天濒临的挑战
今天,青霉素和后续抗生素濒临新的危境——抗生素耐药性。细菌在与抗生素的扞拒中束缚进化,“超等细菌”依然出现,对多种抗生素耐药。形成这一问题的原因包括抗生素糜费、农业中动作饲料添加剂等。
东说念主类正与细菌张开一场武备竞赛。科学家们在开导新抗生素的同期,号召合理使用现存药物。弗莱明的发现精神仍在延续——寻找新的抗菌物资,扶直更多生命。
从1928年阿谁朝晨巧合的一行,到如今人人每年耗尽数百吨抗生素,青霉素的别传仍在无间。正如历史学家评价:“青霉素恒久改动了传染病究诘和休养医学。它改动了患者的盼望和制药公司的结构;它为微生物学孝敬了新认识;况且,它像其他几项科学蹂躏一样ued(中国)官方网站入口,捕捉了公众的思象力。”
金沙电玩城app官方下载